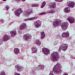

Oocyte vitrification not associated with adverse obstetric or perinatal outcomes
1. There was no increase in adverse obstetric or perinatal adverse outcomes among pregnancies achieved through in vitro fertilization (IVF) with frozen, compared to fresh eggs.
2. Women with ongoing pregnancies conceived using frozen eggs had a higher incidence of invasive procedures, such as amniocentesis compared to women with ongoing fresh cycle pregnancies.
Evidence Rating Level: 2 (Good)
Study Rundown: Oocyte cryopreservation, more commonly known as “egg freezing”, has been a landmark development in assistive reproduction technology (ART) and allowed for more widespread use of in vitro fertilization (IVF). Egg freezing, and subsequent egg banking, offers the possibility of fertility preservation for women, including those with cancer or those who choose to delay childbearing but worry about declining fertility with age. Vitrification, a flash freezing process with greater success rates than traditional slow freezing/cooling methods, has allowed egg freezing to become a more routine and accessible procedure. Despite many successes and advancements, oocyte vitrification is still a fairly new technology such that some clinical questions remain unknown. In this study, the largest sample size to date, researchers set out to evaluate obstetric and perinatal outcomes of babies conceived using vitrified oocytes as compared with fresh oocyte IVF cycles.
After accounting for potential confounders, researchers found no significant difference in clinically relevant obstetric or perinatal adverse outcomes between pregnancies achieved by vitrified and fresh oocytes. Pregnancies from frozen eggs were associated with more invasive procedures and less urinary tract infections than pregnancies from fresh eggs, Strengths include the large sample size and single IVF clinic site, which allowed for control of IVF procedures. Limitations asymmetry in response rates between the groups: 81.6% in women with vitrified oocytes and 50.8% in women with fresh oocyte cycles participated in the study. Additionally, although the IVF procedures were all preformed at one clinic, most women received their obstetric care at their home facility, thus researchers were not able to control for differences in obstetric practices at different hospitals. While this data suggests that there are no adverse pregnancy or perinatal outcomes associated with vitrification, a larger, prospective study with long-term follow up is merited.
Click to read the study in Fertility and Sterility
Relevant Reading: Mature oocyte cryopreservation: a guideline
In-Depth [retrospective cohort]: Researchers collected data on pregnancies between 2007 and 2012 and compared outcomes between those achieved by vitrified (n= 804 pregnancies, 1,027 newborns) and fresh oocytes (n=996 pregnancies,1,224 newborns). Outcomes assessed included pregnancy (i.e. the need for invasive procedures, pregnancy-induced hypertension), delivery (ie preterm births, cesarean section) and neonatal (ie low birth weight, birth defects) adverse events.
Women in the vitrification cohort were more likely to be of advanced maternal age at conception and had an increased incidence of previous miscarriages, while women in the fresh oocyte cohort had a higher proportion of previous preterm births. There was no difference in clinically relevant pregnancy, delivery, or neonatal adverse events between the two groups. Pregnancies achieved from vitrified oocytes had a greater number of invasive procedures (such as chorionic villous sampling or amniocentesis) (OR=2.12, 95% CI=1.41-3.20) and a lower frequency of urinary tract infections (OR=0.51, 95% CI=0.28-0.91).
Image: PD
More from this author: SSRI use during pregnancy not associated with fetal, neonatal or infant mortality, IUD contraception equally effective in teenagers as in older women, More US women using emergency contraception, Updated USPSTF guidelines favor treatment of mild gestational diabetes
©2012-2014 2minutemedicine.com. All rights reserved. No works may be reproduced without expressed written consent from 2minutemedicine.com. Disclaimer: We present factual information directly from peer reviewed medical journals. No post should be construed as medical advice and is not intended as such by the authors, editors, staff or by 2minutemedicine.com. PLEASE SEE A HEALTHCARE PROVIDER IN YOUR AREA IF YOU SEEK MEDICAL ADVICE OF ANY SORT.